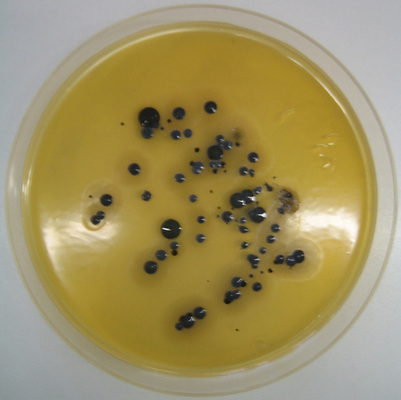

Normalerweise verursachen diese Bakterien keine Infektion. Man kann das Bakterium jeden Tag von anderen Menschen auf die Haut übertragen bekommen. Es kann sich aber auf der Haut eines gesunden Menschen nicht ohne Weiteres einnisten und ausbreiten, da die gesunde Haut und auch die Schleimhaut des Menschen einen Schutz gegen MRSA darstellen (kolonisationsresistent). Deswegen muss auch eine Schwangere oder stillende Mutter keine Angst haben, dass sie den Keim auf ein gesundes Neugeborenes überträgt und dieses daran erkrankt.
Allerdings kann es zu einer Infektion kommen, wenn die Haut nicht intakt ist, also beispielsweise nach einer Verletzung, einer Operation oder bei einem Hautekzem. Solche Infektionen können harmlos verlaufen, bei geschwächtem Immunsystem kann es aber auch zu schweren Verläufen kommen. Gefährlich wird es dann zusätzlich, wenn dieses Bakterium resistent gegen bestimmte Antibiotika geworden ist, wie das bei den Methicillin-resistenten Staphylococcus aureus (MRSA) der Fall ist. (In Deutschland findet man auch den Begriff ORSA für diese resistenten Bakterien.) Seit Mai 2012 darf ein Hausarzt nach entsprechender Qualifizierung Abstriche nehmen und auch abrechnen.
Eine Besiedlung (Kolonisation) bedeutet, dass MRSA auf der Haut oder Schleimhaut des Menschen angesiedelt ist und sich vermehrt, aber keine Erkrankung verursacht. Wie lange eine Person aber kolonisiert ist, kann niemand voraussagen. Ebenfalls ist nicht bekannt, ob für diese transiente Besiedlung irgendwelche Prädispositionsfaktoren vorliegen. Es gibt in Fachkreisen durchaus die Meinung, dass gewisse Gruppen ein Leben lang Träger sind und immer wieder werden, auch nach Behandlung. Daher wird auch diskutiert, ob eine MRSA-Sanierung mit Antibiotika bei gewissen Gruppen, die wir aber noch nicht näher definieren können, überhaupt sinnvoll ist oder ob dies nicht dazu führt, dass immer resistentere MRSA-Formen gezüchtet werden. Chronisch kranke Heimbewohner zählen zu dieser Gruppe und wohl auch Risikogruppen (Handekzem-Kranke oder zu Infekten neigende Beschäftigte im Gesundheitswesen). Solche Patienten nennt man auch MRSA-Träger. Bei einer Infektion dringt der MRSA über die Haut bzw. Schleimhaut in den betroffenen Menschen ein und macht ihn krank. In beiden Fällen müssen dieselben Hygienemaßnahmen durchgeführt werden. Hierzu gehören Waschungen und die Benutzung von antibiotischer oder antiseptischer Nasensalbe; Patienten mit einer Infektion bekommen zusätzlich eine Antibiotikatherapie. In Hausarztkreisen ist es zum Teil sehr umstritten, ob diese Therapie langfristig überhaupt Nutzen bringt.
Jeder, der im Gesundheitswesen tätig ist, hat sich so zu verhalten, dass es nicht zu einer Übertragung von Keimen kommen kann
Damit ist aber auch klar, dass ein kolonisierter Mitarbeiter nicht erkrankt ist. Allerdings ist das Erkrankungsrisiko für einen MRSA-Träger 13fach erhöht! Eine MRSA-Besiedlung verursacht auf jeden Fall ein Behandlungsproblem. Es ist auch nicht notwendig, dass ein MRSA-Patient mit einer Isolierfahrt transportiert wird. Wir sollten jedoch dazu kommen, dass alle Patienten als potenzielle Keimträger behandelt werden, ebenso wie dies für eine potenzielle HIV- oder HCV-Infektion gilt: das heißt, jeder im Gesundheitswesen hat sich so zu verhalten, dass es zu keiner Keimübertragung – weder auf ihn selbst noch auf Mitpatienten – kommen kann. Dies kann m. E. allerdings nur mit einem anderen Personalschlüssel erfolgen.
Laut Robert-Koch-Institut sind MRSA-Untersuchungen beim Personal nur notwendig:
- bei gehäuftem Auftreten (zwei Fälle) in einem Bereich,
- bei chronischem Krankheitsverlauf eines Mitarbeiters (beispielsweise im HNO-Bereich).
Eine routinemäßige Untersuchung von medizinischem Personal auf MRSA ist nicht notwendig (Kategorie IB).
Ich persönlich würde mich aber vor einem geplanten invasiven Eingriff screenen lassen und würde auch jedem Beschäftigten aus dem Gesundheitswesen vor einer elektiven Operation, beispielsweise einer Zahnwurzelbehandlung oder einem Zahnimplantat, ein Screening empfehlen. Das Wissen über die MRSA-Trägerschaft ist zunächst für den einzelnen Patienten selbst wichtig, der vor einer medizinischen Behandlung steht. Infektionen nach medizinischen Maßnahmen sind häufig nicht zu vermeiden und erfolgen am häufigsten durch die Bakterien, die bereits auf dem Menschen selbst leben. Besteht schon bei Krankenhausaufnahme eine MRSA-Besiedlung, so ist eine spätere Infektion mit MRSA die wahrscheinlichste Ursache.
Dies würde ich ausschließlich zum Schutz des Mitarbeiters oder der Mitarbeiterin im Gesundheitsdienst empfehlen, damit eine MRSA-Infektion nicht vorprogrammiert ist. Es ist auch zu empfehlen, dass dieser Abstrich nicht innerhalb der Einrichtung erfolgt, sondern bei seinem oder ihrem behandelnden Arzt. Um es ganz klar zu sagen: Eine Meldepflicht für MRSA-Träger besteht nicht. Abstriche beim Personal sollten aber niemals routinemäßig durchgeführt werden!
Eine Meldepflicht für MRSA-Träger besteht nicht
Das Personal-Screening ist nur ein Baustein für Maßnahmen zur Beendigung eines MRSA-Ausbruchs und sollte wohlüberlegt (d. h. nicht immer bei einem Ausbruch und nicht als Routine) eingesetzt werden.
Laut Gesetz ist niemand direkt für die Abnahme des Abstrichs zuständig. Die Zuständigkeit muss im Hygieneplan festgelegt werden (Betriebsarzt/Krankenhaushygiene?). Auch der Datenschutz muss unbedingt beachtet werden!
Was passiert aber dann mit den positiven Befunden?
- Eine Meldung ans Gesundheitsamt ist nicht notwendig, außer der Keim wurde im Blut/Liquor nachgewiesen.
- Eine Weiterbeschäftigung im Gesundheitswesen ist möglich, jedoch nur in pflegefernen Tätigkeiten. Zur Erfolgskontrolle der Sanierung sind frühestens drei Tage nach Abschluss der Maßnahme, je nach Lokalisation, Kontrollabstriche vorzunehmen. Wird kein MRSA nachgewiesen, ist die Wiederaufnahme der Patientenbetreuung möglich. Weitere Kontrollen sind nach zehn Tagen, einem Monat und drei Monaten zu veranlassen.
- Eine Arbeitsunfähigkeit ist bei reiner Kolonisation nicht möglich.
- Eine Zwangsbeurlaubung ist nicht möglich, aber das Abfeiern von Überstunden ist machbar.
- In seltenen Fällen spricht das Gesundheitsamt ein Beschäftigungsverbot aus. Dazu muss ganz klar nachgewiesen werden können, dass keine pflegeferne Tätigkeit für den Zeitraum bis zur Sanierung möglich ist (§ 31 InfSchG) und der Mitarbeiter andernfalls wieder an seinem Arbeitsplatz eingesetzt werden müsste. Solche Fälle sind mir jedoch nicht bekannt und es ist kaum vorstellbar, dass das Gesundheitsamt eventuell eine Berufsunfähigkeitsrente tragen würde.
Was soll mit einem Beschäftigten passieren, der nicht saniert werden kann? Eventuell muss auch ein Angehöriger des positiven Beschäftigten mitgescreent werden, inklusive Hund und Katze, um eine erneute Übertragung innerhalb der Familie zu verhindern.
Ist eine komplette Sanierung überhaupt möglich, wenn man sich den Fall eines kontaminierten Eichenschrankes vorstellt? Wie soll das gehen?
All diese Punkte sollten zuvor thematisiert und in einem hausinternen Standard, der entwickelt wird, festgelegt werden. Ich würde mich freuen, wenn die BGW zu diesen offenen Punkten Stellung beziehen würde, damit den Beschäftigten im Gesundheitswesen mehr Sicherheit an die Hand gegeben werden kann.
Autorin
Dr. med. Monika Stichert
Arbeits- und reisemedizinische Praxis, Gelbfieberimpfstelle
Pestalozzi Str. 3 – 40699 Erkrath
info@arbeitsmedizin-stichert.de
Weitere Infos und Quellen:
Epidemiologisches Bulletin 36/2008:
https://edoc.rki.de/handle/176904/4433
Epidemiologisches Bulletin 26/2011
www.rki.de/DE/Content/Infekt/EpidBull/Archiv/2011/Ausgaben/26_11.pdf;jsessionid=2CB1276BB4CE3A7E70D37726F2201C7C.2_cid290?__blob=publicationFile
MRSA-Net:
www.mrsa-net.org